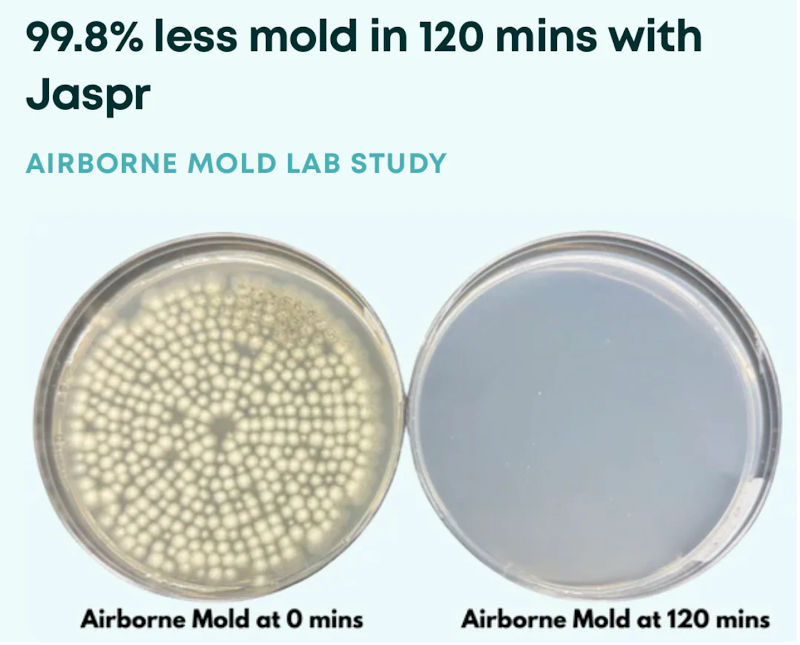
jaspr air purifier review

Recently my teenage son started – and won – a negotiation over bedtime with one sentence. He inherited my old Oura ring last year, and he used the data he’d collected to show me that delaying by 30-45 minutes would align better with his circadian rhythm.
My husband smirked as “sleep latency” casually rolled out of our son’s mouth, because data is one of my love languages.
That’s not to say I prefer graphs over personal experience, I pay close attention to my body’s cues – what helps me feel strong, rested, and nourished – but I also value objective markers and high quality research to help me make decisions.
So when Jaspr announced a sleep study that used Oura ring data to track the impact of their air scrubber, I immediately volunteered to participate. I love data, I love sleep, and I’m always up for a good experiment.
Plus, it’s not every day you see a company willing to test their product in real-world bedrooms where people actually sleep. That’s the kind of transparency I respect.
Jaspr sent me an air scrubber – which is different than an air purifier, as I’ll explain soon – to use throughout the study. I was allowed to keep it as a “thank you” for participating, and after using it for 18+ months, I’m seriously impressed.
Here are seven ways it stands out:
#1 – Independently Tested
Jaspr has undergone multiple rounds of independent testing, with consistently strong results. In one lab test, it achieved:
✅ 97.1% mold removal in 1 hour
✅ 99.8% mold removal in 2 hours
✅ 100% elimination in 3 hours
The results are available on this page if you want to check them out.
Jaspr also filters a wide range of everyday air pollutants, including
- Microplastics
- Dust, pollen, & other allergens
- Smoke particles (wildfire, cigarette, incense/candles)
- Pet dander
- Volatile Organic Compounds (VOCs) from everyday things like cooking, furniture off-gassing, cleaning products, paint, and building materials
Also, in the sleep study I mentioned above – participants (that’s me!) on average fell asleep faster, stayed asleep longer, and got more deep sleep.
#2- Adapts To Your Environment

Jaspr doesn’t just run on autopilot – it adjusts as your environment changes. It uses built-in sensors to continuously monitor indoor air quality, including microscopic airborne particles (often called PM2.5 – things like cooking smoke, dust, and fine pollution) and VOCs, which are gases released from furniture, building materials, cleaning products, and everyday life.
When the air changes, Jaspr adjusts automatically. The display shifts from green to yellow or red and shows a number that reflects how many tiny particles it’s detecting in real time.
My kids love watching the light turn yellow when we cook, then drift back to green as the air clears. We love bacon – Jaspr doesn’t. 🙂
One quick note: Although this feature is technically called Smart Mode, it doesn’t increase EMF exposure. There’s no need to connect to an app via bluetooth or Wifi – the purifier doesn’t need any of those things to work.
And if you prefer more control, you can manually adjust the fan speed to whatever level feels right.
#3 – Whisper Quiet

Most of the time, Jaspr runs on its quietest setting, which is very quiet. If you’re like me you’ll barely know it’s on – which is perfect if you’re using it in a bedroom, office, or anywhere quiet matters.
#4 – Dark Mode For Sleep
As someone who put these LED light dimming stickers on all the bright indicator lights that seem to be standard on electronics these days, I appreciate that Jaspr comes with a built-in dark mode.
At night, one quick touch will turn off the display lights so that they don’t disrupt your sleep. One small area stays very dimly lit so you can find the button to turn the lights back on. If you want complete darkness, just cover it with a quarter or something similar.
#5 – Durable, Clean Design
Unlike most purifiers, which are pretty clunky, it has a minimalist design that blends into just about any decor style.
The exterior is steel, which can be endlessly recycled without losing strength (unlike plastic, which often ends up in landfills).
Also, it uses a 360° air intake, pulling air from all sides so you can place it against a wall without restricting airflow.
#6 – More Than A Typical Air Purifier
When you go to Jaspr’s site, you’ll see it’s described as an air scrubber, not an air purifier. If you’re thinking, “So . . . what exactly does that mean?” here’s how they explain it:
Air purifiers vary widely in quality. Most are made of plastic and designed to be compact, lightweight, and affordable. They often market large square footage coverage, but without clear context. These numbers frequently overlook critical variables like ceiling height, airflow efficiency, or actual air changes per hour (ACH) – a measure hub how often the air in a room is completely replaced.
For example, a purifier might claim to cover 1500 square feet but only deliver one air change per hour, which may not be sufficient in environments with ongoing pollutant sources. This lack of transparency is a common issue in the consumer air purifier market.
An air scrubber, by contrast, is a much more robust system originally designed for industrial and commercial use. Air scrubbers are built to handle high, contaminant loads, such as during . . . wildfire cleanup, or renovation projects.
They operate using high-powered fans and heavy duty filters to rapidly cycle and clean large volumes of air – often achieving multiple air changes per hour.
#7 – Lifetime Warranty (With filter subscription)
Maintenance is easy – the filter only needs to be replaced about every six months, and it takes less than a minute. If you prefer not to think about it, their subscription automatically sends a new filter on schedule and includes a discount.
The subscription also activates their lifetime warranty. If your purifier ever has an issue, they send a replacement and cover the return – no extra fees, no complicated process.
And I really do mean that.
Earlier this year, my husband and I bought a Jaspr for a space outside our home where our boys spend a lot of time. After a while it developed a slight noise, so he reached out to ask about an exchange.
They shipped a replacement quickly and paid to have the original returned.
My husband placed the order and handled the support request through his own account, so Jaspr had no idea I was paying attention – or that I would eventually write about the experience.
That mattered to me, because their FAQ page says, “Your Jaspr is covered for as long as your filter subscription is active. No catches, no hidden costs, ever.”
A promise like that only means something if it’s kept for every customer – not just when a company knows the interaction might end up in a review.
Air purifiers are an investment, so it’s not a small thing to have a warranty that actually feels like a warranty.
#8 – Free Shipping + Money Back Guarantee
Jaspr air scrubbers come with a 30-day money back guarantee, so you get to try it out and – if it’s not the right fit – you can send it back. (Just hang on to the box!)
Shipping is also free in the continental U.S. and Canada.
What does Jaspr’s 3-in-1 filter include?
Jaspr keeps things simple with a single, easy-to-replace filter that handles three stages of filtration, so you get strong air purification without juggling multiple parts.
The heavy-duty filter (about four pounds) combines three layers designed to work together:
Stage 1: The Pre-Filter
This outer layer captures larger particles like dust and pet hair. It also protects the layers underneath, helping the main filter last longer and maintain performance over time.
Stage 2: High-Efficiency Particulate Air (HEPA) Filter
Jaspr uses a HEPA filter that captures mold spores, pollen, pet dander, and other airborne irritants.
HEPA filters trap a minimum of 99.97% of particles that are 0.3 microns in diameter. For reference, a human hair is about 70 microns thick.
Here’s how Jaspr explains that in terms of real-world performance:
If an intake of air containing 10,000 particles of 0.3 microns in diameter passed through a HEPA filter, a maximum of only 3 out of the 10,000 particles would be allowed to pass through the filter.”
Stage 3: Carbon Filter
This is the part of the filter that targets VOCs – the invisible chemicals that can come from cooking, furniture off-gassing, cleaning supplies, or paint (though I always recommend choosing non-toxic paint options like ECOS whenever possible).
The carbon filter is interlaced within the HEPA filter, capturing and binding to pollutants like formaldehyde while also neutralizing odors.
When I first saw that they use about a pound of carbon, I wanted to know why. Some brands use more, so I wanted to understand the thinking behind the design.
I found a voice note from Jaspr’s founder explaining their approach – including why they chose that carbon load and why they use an H12 filter instead of an H13 or higher.
If you want behind-the-scenes insight into the tradeoffs (airflow, noise, and real-world performance), you can listen to it HERE.
The short version: they prioritized strong airflow, quieter operation, and the ability to clear fine particles quickly – the things most people notice day to day.
If you’re considering a Jaspr

After using Jaspr for more than a year – through a sleep study, controlled burns in nearby forests, everyday cooking, and normal family life – I’ve been consistently impressed with both the air scrubber and the company behind it.
That’s why when my daughter moves to college next year, she’ll be bringing her own Jaspr with her.
If indoor air quality is something you’ve been meaning to prioritize, this is a well-built, performance-focused option that’s designed to last.
One of the biggest reasons I feel comfortable recommending Jaspr is their warranty. A truly good air purifier / scrubber is an investment, but as long as your filter subscription is active, your unit stays covered under their lifetime support policy.
In our experience, the process is refreshingly easy when you actually need it. If you decide it’s a fit for your home, use code MP to save $250.




Always appreciate your focus on high quality research on all things wellness. We have an air scrubber that we used along with intense personal protective equipment when renovating a space with known asbestos. I really didn’t consider that air scrubbers could be used for everyday air filtration so this is intriguing. We’ve been considering in HVAC in-duct photocatalytic cells for air purification but there is some concern with ozone. Definitely going to look into this.